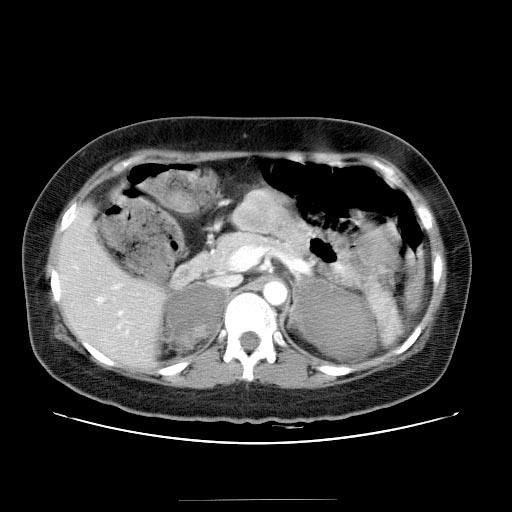
tomography

La cirrosis hepática es una enfermedad crónica del hígado que se caracteriza por la formación de cicatrices en el tejido hepático. Esta afección puede ser causada por diversas condiciones, como la hepatitis crónica, el consumo excesivo de alcohol, la enfermedad del hígado graso no alcohólico y otras enfermedades hepáticas. En este artículo, exploraremos cómo la tomografía, una técnica de imagenología médica avanzada, juega un papel crucial en el diagnóstico y la evaluación de la cirrosis hepática.
Diagnóstico Inicial de la Cirrosis Hepática
El diagnóstico de la cirrosis hepática a menudo comienza con la evaluación de los síntomas clínicos y los antecedentes médicos del paciente. Sin embargo, para confirmar la presencia de cirrosis y determinar su gravedad, se requieren pruebas de imagen. La tomografía es una de las herramientas más utilizadas para este propósito.
Identificación de Signos de Cirrosis en la Tomografía
La tomografía abdominal proporciona imágenes detalladas del hígado y los órganos circundantes. En pacientes con cirrosis hepática, las imágenes de tomografía pueden revelar signos característicos de la enfermedad. Estos signos incluyen la presencia de cicatrices hepáticas (fibrosis), agrandamiento del bazo (esplenomegalia), acumulación de líquido en la cavidad abdominal (ascitis) y cambios en la morfología del hígado.
Evaluación de la Gravedad de la Cirrosis
Una vez que se ha confirmado la presencia de cirrosis hepática, es importante evaluar la gravedad de la enfermedad. La tomografía permite a los médicos determinar el grado de fibrosis y evaluar el estado del hígado. La escala más comúnmente utilizada para medir la gravedad de la cirrosis es la escala de Child-Pugh, que se basa en la presencia de síntomas y hallazgos en las imágenes de tomografía.
Detección de Complicaciones y Anomalías Asociadas
La cirrosis hepática puede llevar a una serie de complicaciones graves, como la formación de varices esofágicas, trombosis de venas hepáticas y hepatocarcinoma (cáncer de hígado). La tomografía es útil para detectar estas complicaciones y determinar si se requiere tratamiento adicional, como la colocación de un stent para las varices esofágicas o la evaluación de la extensión del cáncer de hígado.
Planificación de Intervenciones y Tratamiento
En casos de cirrosis hepática avanzada con complicaciones graves, como la formación de ascitis o trombosis de venas hepáticas, la tomografía juega un papel importante en la planificación de intervenciones médicas o quirúrgicas. Las imágenes de tomografía proporcionan información esencial para guiar procedimientos como la paracentesis (drenaje de líquido abdominal) o la colocación de un TIPS (shunt transyugular intrahepático portosistémico) para tratar las venas hepáticas obstruidas.
Seguimiento de la Enfermedad
El seguimiento regular de los pacientes con cirrosis hepática es esencial para evaluar la progresión de la enfermedad y la respuesta al tratamiento. La tomografía se utiliza en el seguimiento de la cirrosis para evaluar cambios en la fibrosis hepática, la presencia de complicaciones y la eficacia de las intervenciones médicas.
El seguimiento regular de los pacientes con cirrosis hepática es esencial para evaluar la progresión de la enfermedad y la respuesta al tratamiento. La tomografía se utiliza en el seguimiento de la cirrosis para evaluar cambios en la fibrosis hepática, la presencia de complicaciones y la eficacia de las intervenciones médicas.
Conclusiones
En resumen, la tomografía es una herramienta esencial en el diagnóstico y la evaluación de la cirrosis hepática. Proporciona imágenes detalladas que permiten identificar signos de cirrosis, evaluar la gravedad de la enfermedad, detectar complicaciones y guiar el tratamiento. El uso adecuado de la tomografía en la atención de pacientes con cirrosis hepática es fundamental para mejorar la calidad de vida de estos pacientes y brindarles la atención médica que necesitan.
 Enfermedad de Lyme y su Variedad de Síntomas
Enfermedad de Lyme y su Variedad de Síntomas La relevancia de las pruebas COVID
La relevancia de las pruebas COVID La enfermedad de Chagas, causada por el parásito Trypanosoma cruzi, es una afección transmitida por insectos en América Latina. Dada su naturaleza, es vital contar con herramientas de diagnóstico precisas. En este artículo, exploraremos el papel del
La enfermedad de Chagas, causada por el parásito Trypanosoma cruzi, es una afección transmitida por insectos en América Latina. Dada su naturaleza, es vital contar con herramientas de diagnóstico precisas. En este artículo, exploraremos el papel del